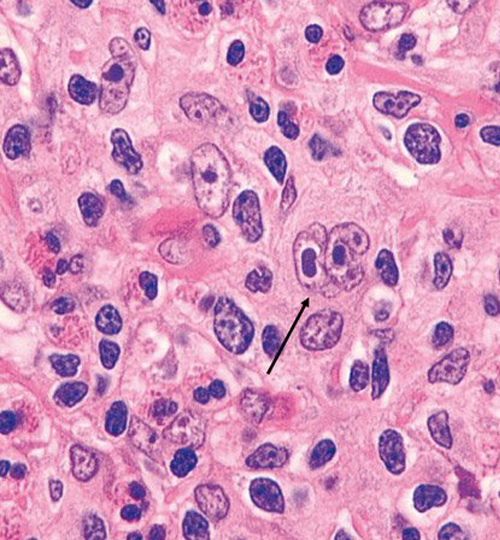
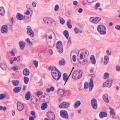

Ce cancer rare a suivi l’évolution des progrès de la cancérologie et est considéré comme le premier cancer guéri, permettant, de ce fait, la nécessaire prise en compte des séquelles des thérapeutiques. Les études de recherche clinique ont permis de définir le traitement le « plus juste » pour maintenir la guérison des patients et diminuer les séquelles. Au cours des dix dernières années, la thérapeutique a intégré des stratégies d’immunothérapie grâce à une meilleure compréhension de la physiopathologie de ce très mystérieux cancer. Le point dans ce dossier à l’occasion du septembre rouge, le mois de sensibilisation aux cancers du sang.
À lire :
Fermé C. Historique du lymphome de Hodgkin. Rev Prat 2023 ;73(6) ;608 - 10.
Ghesquières H. Épidémiologie du lymphome de Hodgkin. Rev Prat 2023 ;73(6) :611 - 4.
Ghesquières H. Mieux comprendre les mécanismes biologiques. Rev Prat 2023 ;73(6) :615 - 6.
Ghesquières H. Diagnostic et bilan préthérapeutique du lymphome de Hodgkin. Rev Prat 2023 ;73(6) :617 - 20.
Kanoun S. Tomographie par émission de positons : une place centrale dans le bilan et l'évaluation. Rev Prat 2023 ;73(6) :621 - 4.
Rossi C, Casasnovas O. Traitement de première ligne du lymphome de Hodgkin classique. Rev Prat 2023 ;73(6) :625 - 32.
Deau Fischer B. Rechute du lymphome de Hodgkin : traitements de deuxième ligne et suivantes. Rev Prat 2023 ;73(6) :633 - 6.
Ghesquières H. Suivi au long cours des patients traités pour un lymphome de Hodgkin. Rev Prat 2023 ;73(6) :637 - 40.
Michot JM, Lazarovici J. Toxicité des thérapies ciblées et de l’immunothérapie par inhibiteurs des points de contrôle dans le lymphome de Hodgkin. Rev Prat 2023 ;73(6) :641 - 50.
Rousset-Jablonski C. Troubles de la fertilité et gonadiques chez les patients atteints d’un lymphome de Hodgkin. Rev Prat 2023 ;73(6) :651 - 3.
Ghesquières H. Lymphome de Hodgkin : les 10 messages clés. Rev Prat 2023 ;73(6) :654.